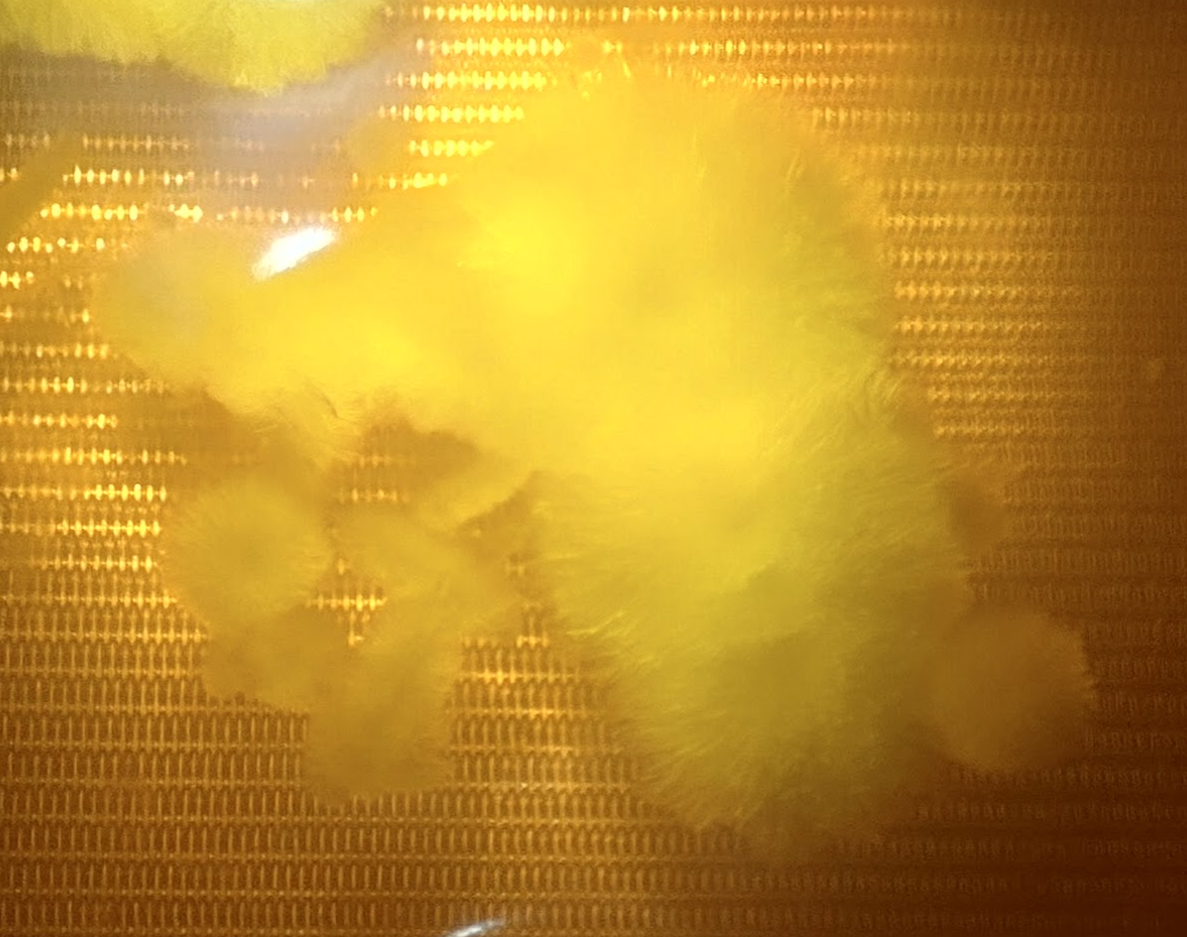
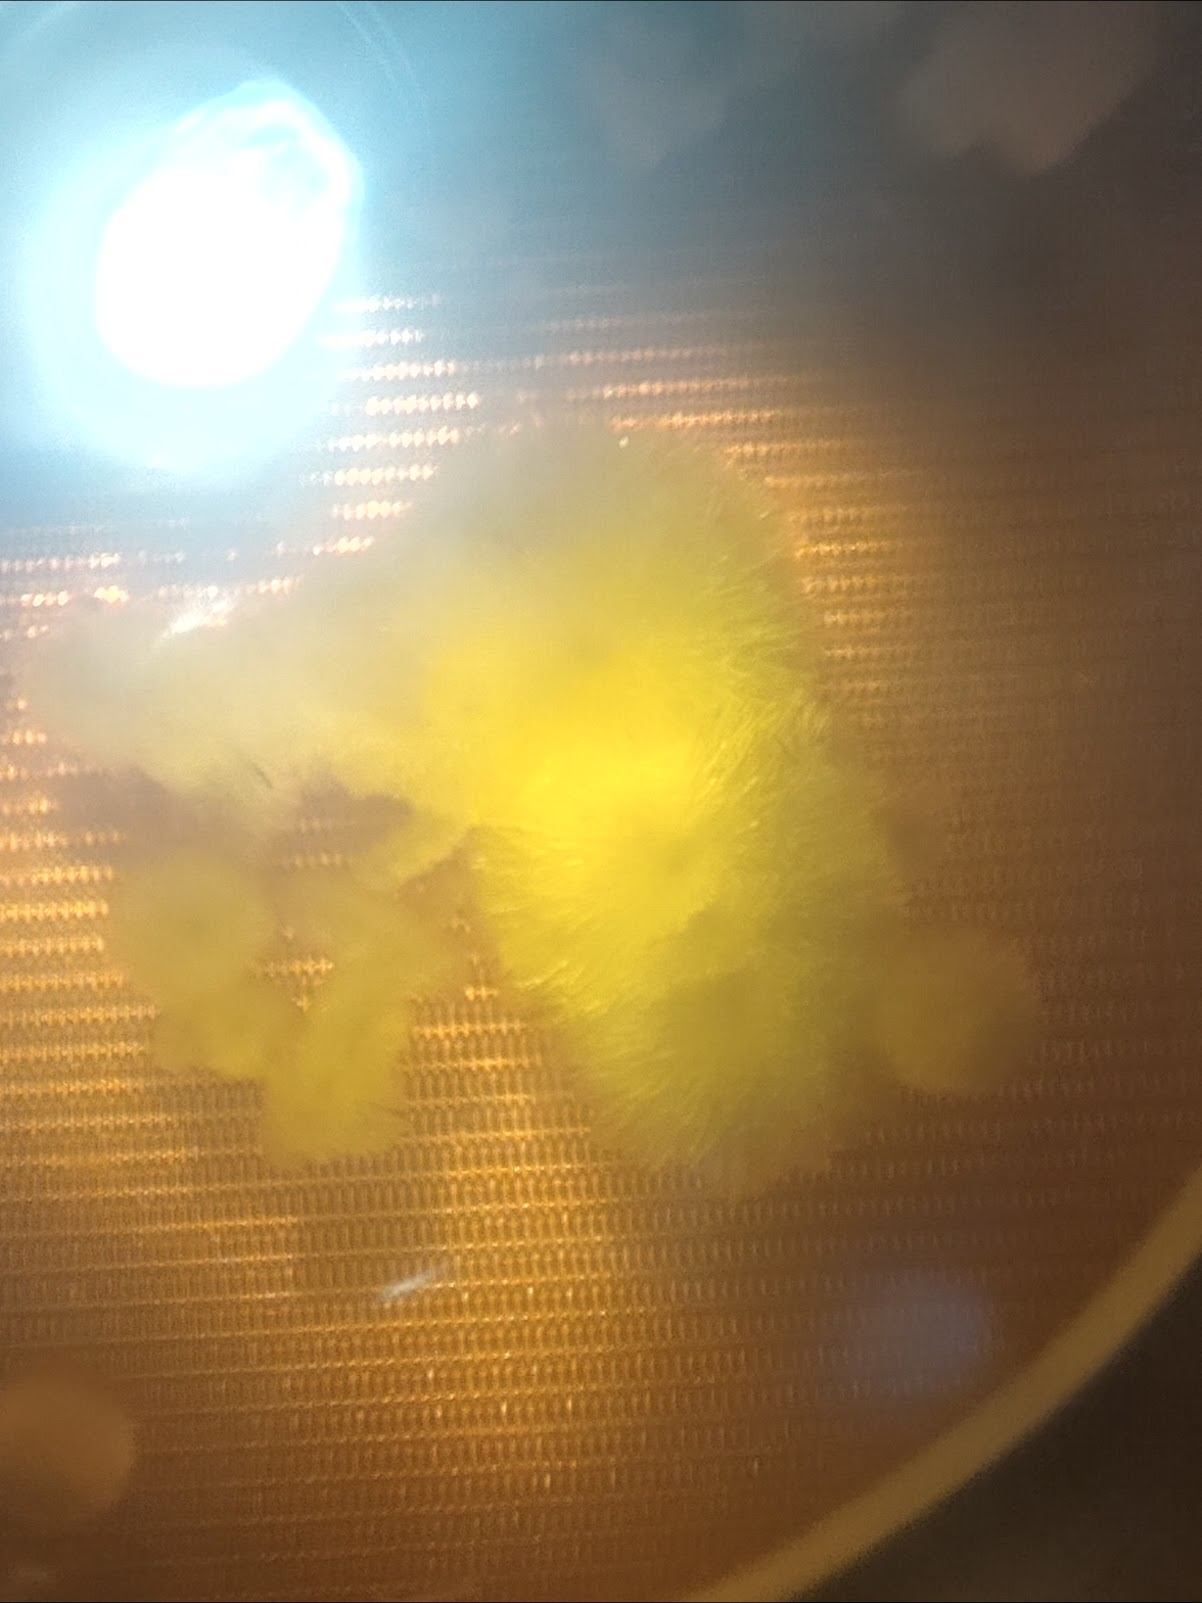

Chapter 6: Isolation (Evaporative & Cooling Crystallization)
, by Avery Benitez, 29 min reading time

, by Avery Benitez, 29 min reading time

INTRODUCTION TO CRYSTALLIZATION

Isolation represents the final step of refinement for botanical extract resulting in a highly refined concentrate of the target compound reaching upwards of 99% purity. While Isolation of target compounds can be achieved via fractional distillation or chromatography, the focus of this section will be on crystallization as means of Isolation. Crystallization is a purification technique used to isolate crystalline compounds from a solution. This is achieved by manipulating the solubility of the target compound when dissolved in a crystallization solvent. This is most commonly achieved through the evaporation of solvent or the cooling of the solution to achieve supersaturation of the target compound within the solution.
Crystallization utilizes the concept that different compounds have different solubilities within the same solvent and that only molecules of the same crystalline compound will align into the lattice structure of the crystal formation; impurities can only stick to the outside of the crystal lattice or remain within the solution. In practice, crystallization of a target compound is performed by achieving supersaturation via either the evaporation of the solvent from the solution or cooling of a solution to reduce its solubility to the point of supersaturation.
Supersaturation occurs when the solute concentration of a solution is pushed beyond the solvent's solubility capacity at a given temperature. When a solution is supersaturated with solute, it is pushed beyond its maximum saturation capacity. Saturation is defined as the maximum amount of a solute that will dissolve in a given amount of solvent at a specific temperature. A solution is considered saturated at a given temperature when no more solute can be dissolved within the solution. A solution can become supersaturated when the solvent is evaporated, or the solution is cooled, reducing its saturation capacity beyond the point of saturation. When a solution becomes supersaturated, it contains more solute than the solvent is capable of holding. This results in the clustering and alignment of a crystalline compound within the solution, producing a crystalline structure precipitating out of the solution. This process of precipitating a crystalline compound out of a solution is referred to as crystallization.

Crystallization is when solids form due to the alignment of molecules into a structure known as a crystal. The most common process of crystallization involves precipitating a crystalline structure from a solution. Crystallization within a solution occurs in three major steps:
The supersaturation of the solution.
The spontaneous precipitation of a crystalline structure within the solution referred to as nucleation.
The increase in the size of the initial crystalline structure referred to as crystal growth.
The attributes of the resulting crystal depend largely on factors of supersaturation such as temperature, and fluid evaporation. Typically, a slower temperature ramp or fluid evaporation forms a larger crystalline structure, triggering more crystal growth rather than nucleation If the size of the crystalline structure is of no concern, the crystallization process can be accelerated by dropping the temperature of the solution rapidly resulting in more nucleation sites and a preponderance of smaller crystalline structures.

Nucleation occurs within a solution when crystalline solute molecules align and assemble within a supersaturated solution to form a crystalline structure. Thermodynamic and chemical properties drive both nucleation and crystal growth.The supersaturation level of the solution drives the initiation of nucleation. During nucleation, molecules of the same compound cluster within a solution arranging themselves into a crystalline structure. Nucleation happens spontaneously over time when a solution is supersaturated, or initiated by cooling the solution past the point of supersaturation.
For most chemical compounds dissolved in most solvents, direct solubility or the solubility threshold of a compound increases and decreases within a solution as the solution's temperature increases or decreases. This allows for supersaturation to be achieved by reducing the temperature of the solution. As the solution is cooled, its saturation capacity is lessened until the solution reaches the point of supersaturation. When supersaturation of a solution is achieved, the solution reaches a point where it can no longer keep the entirety of the target crystalline compound dissolved within the solution resulting in precipitation of crystalline structure from the solution. This initial formation of a crystalline structure is referred to as nucleation.
Once nucleation of the initial crystalline structure is achieved, and crystal growth slows, further crystal growth can be attained through greater supersaturation. Crystal growth is a dynamic process occurring in equilibrium with a solution's saturation capacity where the target crystalline molecules precipitate out of the solution and dissolve back into the solution based on the solution's level of supersaturation. This process is insensitive to a change in temperature as long as the saturation state remains unchanged. Supersaturation is the main driving force behind crystal growth. Once crystal growth has slowed, solvent evaporation or solution cooling can be utilized to supersaturate the solution further and promote more crystal growth. Careful control of the supersaturation level of the solution is critical to ensure the desired crystal size distribution.
Once satisfied with crystal precipitation, the crystals can then be separated from the solution via vacuum filtering or centrifugal separation resulting in a separation of the target crystalline compounds and the remaining solution referred to as mother liquor. The mother liquor solution often contains a small amount of the target crystalline compounds and other valuable botanical constituents found within the starting solute. Mother liquor can be collected over time and further purified, or it can be purged of solvent and utilized for its other constituents.
When the separation of the target crystalline compound and mother liquor has been achieved, the crystals can optionally be rinsed with a chilled crystallization solvent like pentane or heptane to wash impurities from the surface of the crystal to increase crystal purity further.
At this point, the crystals are then vacuum purged at the boiling point of the crystallization solvent to remove residual solvent from the crystals before preparing a sample for third-party analysis to ensure their purity and absence of residual solvent. Large crystals may need to be ground down to a fine powder to purge all residual solvent from the crystalline compound. Crystallization is a dynamic process that can be accomplished in various ways using an assortment of different solvents. This section will focus on the two most common in botanical extract refinement: evaporative crystallization utilizing butane and cooling crystallization utilizing heptane.
General Crystallization Steps

Chapter 6: Isolation Glossary
Biomass: Generic plant matter used in extraction. Composed of flowers, leaves, and other plant parts.
EVAPORATIVE CRYSTALLIZATION
Jacketed Diamond Miner By BVV
Evaporative crystallization utilizes the evaporation of the crystallization solvent in order to supersaturate a solution and achieve crystallization of a target crystalline compound. Supersaturation occurs when the solute concentration is pushed beyond the solvent's solubility capacity at a given temperature. When a solution is supersaturated, it holds more dissolved solute than its maximum saturation capacity, which triggers the precipitation of a crystalline structure out of the solution. Saturation is defined as the maximum amount of a solute that will dissolve in a given amount of solvent at a specific temperature. A solution is considered saturated at a given temperature when no more solute can be dissolved within the solution.
Evaporative crystallization achieves supersaturation of a solution by the evaporation of solvent from the solution reducing the solution's overall amount of solvent. Supersaturation is achieved when enough solvent within a solution is evaporated, thus pushing the solution beyond its saturation capacity. Upon supersaturation, a solution contains more dissolved solute than solvent is capable of holding. This results in the clustering and alignment of a crystalline compound within the solution producing a crystalline structure precipitating out of the solution.
For teaching purposes, let us say 5lbs of butane can dissolve a maximum of 1lb of a target crystalline compound at 24C/75F inside a closed system. This would be its maximum saturation capacity; it is incapable of dissolving any more of that compound. If we were to evaporate off 1lbs of the butane, the remaining solution would become supersaturated, meaning that the solution contains more dissolved solute than it is capable of maintaining dissolved. Once supersaturation of the solution is achieved, it triggers the clustering and alignment of a crystalline compound within the solution, resulting in a crystalline structure precipitating out of the solution.

Crystals By Chemtek
This process of precipitating a crystalline compound out of a solution is referred to as crystallization. Crystallization is the process by which a solid forms, due to the alignment of molecules into a structure known as a crystal. During evaporative crystallization, this process occurs in three major steps:
The supersaturation of the solution
The spontaneous precipitation of a crystalline structure within the solution referred to as nucleation
The increase in the size of the initial crystalline structure referred to as crystal growth achieved via further supersaturation
The attributes of the resulting crystal depend largely on factors of supersaturation achieved via fluid evaporation. Typically, slower fluid evaporation forms a larger crystalline structure, triggering more crystal growth than nucleation. The supersaturation level of the solution drives the initiation of nucleation. As a solution becomes more supersaturated, molecules of the same crystalline compound cluster within a solution arranging themselves into a crystalline structure. Nucleation happens spontaneously over time when a solution is supersaturated. This process can take days or weeks, depending on the starting purity of the solution and its level of saturation.
Prior to nucleation, the solvent should be slowly evaporated from the solution until nucleation spontaneously occurs. Once nucleation of the initial crystalline structure is achieved, and crystal growth slows, further crystal growth can be attained through greater supersaturation. Crystal growth is a dynamic process occurring in equilibrium with a solution's saturation capacity. The target crystalline molecules precipitate out of the solution and dissolve back into the solution based on the solution's level of supersaturation. Supersaturation is the main driving force behind crystal growth. Once crystal growth has slowed, solvent evaporation can be utilized to supersaturate the solution further and promote more crystal growth. Careful control of the supersaturation level of the solution is critical to ensure the desired crystal size distribution.
Evaporative Crystallization By Oleum Extracts
The process of nucleation can be skipped through the introduction of a seed crystal of the target compound, acting as a starting point for crystal growth to occur. Regardless of seeding once a crystal has been nucleated. Crystal growth is accelerated by further evaporating solvent from the solution slowly or incrementally. Commonly this process is performed by a quick off-gassing of the vessel to supersaturate the solution further. This is typically performed once crystal growth has halted to re-accelerate crystal growth. As the crystals grow, light agitation can also be utilized to negate the clumping of crystals.
Evaporative crystallization is most commonly performed with a highly volatile solvent like butane and propane. These light hydrocarbons' low boiling points are ideal for evaporative crystallization because the solvent can be evaporated from the solution easily to increase supersaturation without overheating the solution and redissolving the crystals. This section will utilize butane as both our crystallization solvent and our extraction solvent with evaporative crystallization in mind. When planning to perform evaporative crystallization after an initial butane extraction the initial extraction of the target crystalline compound should be performed to limit the pickup of impurities and maximize the concentration of the target crystalline compound. This is most commonly achieved by chilling the butane prior to extraction and refining the resulting solution through inline adsorbent filtration.
Typically, the greater the solution’s starting purity, the greater the isolation yield. Once the refined extraction solution has made its way to the collection vessel, the solvent recovery process will be initiated, recovering the bulk of the solvent, leaving enough butane remaining in the solution to achieve supersaturation. Evaporating the majority of the solvent from the solution increases the solute concentration past its solubility threshold, achieving supersaturation. Once near supersaturation is achieved, typically gauged by a slight increase of viscosity of the solution, the supersaturated solution is then transferred to a pressure vessel, and the slow evaporation of solvent further supersaturates the solution until nucleation is achieved. After the initial nucleation is achieved, small amounts of solvent can be evaporated from the solution once crystal growth slows, increasing supersaturation and re-initiating crystal growth.
Once satisfied with crystal precipitation, the remaining mother liquor solution can be separated via vacuum filtration or centrifugal separation before vacuum purging both products separately. Once both products have been sufficiently purged, a sample of both should be sent out for third-party analysis to confirm potency and status free of residual solvents.

EVAPORATIVE CRYSTALLIZATION STANDARD OPERATING PROCEDURE
Purpose
The purpose of this procedure is to provide detailed instructions for butane crystallization from an initial butane extraction.
Scope
This procedure applies to all lab technicians tasked with evaporative crystallization of a botanical extract.
Definitions/Acronyms
Personal Protection Equipment (PPE) Items worn to protect employees from exposure to hazardous materials and prevention of injury.
Safety Data Sheet (SDS) Provides useful information on chemicals, describing the hazards the chemical presents, and giving information on handling, storage, and emergency measures in case of an accident.
Safety
SDS Sheets: Butane SDS:
PPE: The following should be worn by all lab personnel while extracting and performing this crystallization procedure :
Protective eyewear
Lab coat
Gloves
Preparation and Use:
Target compounds will be extracted from biomass material with butane as the solvent. The recovery of the solvent from the solution will be done in a controlled manner to achieve supersaturation. The supersaturated solution will be stored under pressure for a period of time allowing for crystallization to occur.
Concentration- Use a High Purity 99.5% Butane (BVV)
Quantity- 5lb of Butane per 1lb of biomass
Frequency- An initial volume of solvent is used, no more is added.
Location- Extraction occurs within a C1D1 environment, inside of a closed-loop hydrocarbon extractor (BVV). Crystallization occurs in a secondary pressure-rated vessel (BVV) inside an appropriately rated C1D1 explosion-proof environment.
Potential Hazards and Risks
See Butane SDS for detailed risks.
6. Preparation
1. Load the material column with fresh biomass packing the material tightly and evenly.
2. Assemble the closed-loop extractor and pressure test the system at 100 PSI for at least an hour to ensure the system is assembled correctly with no leaks. If pressure drops, proceed to identify the leak with soapy water and disassemble and reassemble as necessary. If pressure is held, depressurize the system and proceed to the next step.
3. Attach a spark-free vacuum pump to the collection base of the closed-loop system and open all process flow valves from the collection vessel to the source solvent tank. This will ensure the solvent tank valve is fully closed before pulling the entire system under vacuum. Once the system has reached -30mmHg, close all processing flow valves on the system isolating each vessel, and turn off the spark-free vacuum pump.
3. Proceed to chill the extraction solvent to (-30C or colder) through the use of dry ice or an appropriately sized chiller.
5. Once the extraction solvent has been sufficiently chilled, remove the solvent tank from the chilling bath, place it onto a refrigerant scale and record the starting weight.
7. Procedure
1. If possible, pressurize the solvent tank with nitrogen to 20 PSI. Open the liquid injection valve on the material column and pass the solvent through the material column at a 5:1 ratio (solvent: material).
2. After initial saturation of the material column, slowly open all processing flow valves from the material column, through the color remediation column, to the collection vessel and send the solution through an inline color remediation column directly into the collection vessel. Add additional nitrogen back pressure as necessary to collect the entirety of the extract solution.
3. Once the entirety of the solution has entered the collection vessel, close the collection vessel input valve and open recovery line valves from the collection base to the LP tank.
4. Turn on the heated recirculator, set the temperature to 50C/122F, and open all the recirculation valves to apply heat to the collection vessel.
5. Recover the majority of the starting solvent until supersaturation of the solution is achieved, indicated by a slight increase in viscosity, ensuring butane remains in the solution before closing recovery line valves.
6. Connect a pressure-rated crystallization vessel to the output of the collection base and send the supersaturated solution to the pressure-rated crystallization vessel.
7. Offgas the vessel in a C1D1 rated extraction booth for 1-2 hours until the solution stabilizes before sealing the vessel.
8. Ensure the vessel is completely sealed and store it for 1-2 weeks at 27-30C/80-86F, If crystallization doesn't occur off-gas the vessel to supersaturate the solution further and wait until crystals spontaneously nucleate.
9. Once nucleation has been achieved and crystal growth has diminished off-gas the vessel incrementally evaporates off small amounts of solvent to increase supersaturation and reinitiate crystal growth.
10. As the crystals grow, lightly agitate the solution to reduce crystal clumping as necessary.
11. Once desired crystal growth has been achieved, pour off the mother liquor into a pyrex dish and vacuum purge the extracts separately at 80-100F under full vacuum for 24-72 hours as necessary until no residual solvent remains.
12. Store crystals in a cool dark place to limit degradation.
13. Send out a sample for lab testing to confirm purity and ensure all residual solvent has been removed.

COOLING CRYSTALLIZATION

5L Asahi Glass Benchtop Filter Reactor System By Cascade Sciences
Cooling crystallization is a purification technique utilized across many industries to isolate target crystalline compounds. In botanical extract refinement, this is typically performed by dissolving a highly refined distillate above 80% purity of the target crystalline compound into a crystallization solvent by applying heat and cooling the solution to achieve supersaturation of the solution resulting in the precipitation of the target crystalline compound.
In order to perform an efficient cooling crystallization, the starting solution must be relatively pure, with the higher the starting purity, the better. Typically a highly refined distillate with greater than 80% purity of the target crystalline compound will be used as input to perform a cooling crystallization. The process of cooling crystallization starts by first dissolving the high purity concentrate of the desired crystalline compound into the crystallization solvent through the application of heat and incrementally cooling the solution to achieve supersaturation resulting in the target compound precipitating out of the solution.
Cooling crystallization is typically performed utilizing a jacketed vessel with stirring capability where the crystallization is performed. A high-powered refrigerated heated circulator controls the temperature of the vessel to dissolve the solute into the crystallization solvent and trigger the crystallization process via cooling. A vacuum filtration apparatus is used to separate the resulting crystals from the mother liquor solution. A vacuum oven is utilized to purge the resulting crystals and mother liquor solution of residual crystallization solvent.
Solubility Curve By Mettler Toledo
In order to perform a cooling crystallization, the target crystalline compound we are looking to isolate needs to be dissolved into a solvent that the target compound is soluble in when heated but is insoluble in the same solvent at chilled temperatures. The more insoluble at lower temperatures, the better, as this improves the theoretical yields over a practical temperature change by driving more of the target crystalline compound out of solution.
The ideal cooling crystallization solvent allows for the target compound to be fully dissolved within the solvent, forming a solution through the application of heat while triggering the precipitation of the same compound by reducing its solubility via cooling. The hydrocarbon solvents pentane and heptane are commonly utilized to perform cooling crystallization of nonpolar crystalline botanical compounds.
In most cases, these solvents are effective because they allow for the solubility of a compound to be increased through heat and decreased through cooling. This solubility difference between temperature ranges is the basis of cooling crystallization. This allows a crystalline compound to be dissolved with heat and precipitated from the solution when cooled.

Nucleation Occurring
As the solution is cooled, its solubility is reduced until it becomes supersaturated. It reaches the point where the solution can no longer maintain the target crystalline compound dissolved within the solution. This process initiates the clustering and alignment of a crystalline compound within the solution resulting in a crystalline structure referred to as nucleation.
During a cooling crystallization, the resulting crystal size and structure are governed by the relative rates of nucleation and crystal growth. These, in turn, are driven thermodynamically by the level of supersaturation. Nucleation tends to dominate at high supersaturation levels, giving rise to a preponderance of smaller crystals. At low supersaturation levels, crystal growth tends to dominate, resulting in fewer but larger crystals. Typically a cooling crystallization will be initiated by cooling at a constant predetermined rate over a predetermined temperature range. While this is quite straightforward from a process control perspective, it often means that supersaturation levels and the relative rates of nucleation and growth can vary during cooling.
Crystal Growth Occurring
After the cooling process is complete and the desired crystal precipitation is achieved, the crystal solution is then vacuum filtered to separate the remaining mother liquor solution from the crystals. Once separation of the crystals and mother liquor solution is achieved, the freshly harvested crystals are then rinsed with chilled crystallization solvent. This will remove impurities outside the crystals before vacuum purging the crystals under full vacuum at or near the boiling point of the crystallization solvent to remove any traces of residual solvent.
After the vacuum purging process is complete, a sample of the crystals can be prepared for independent third-party testing to ensure the crystals are of the highest purity and free of residual solvent. If the desired potency is not obtained, the crystals can be redissolved in crystallization solvent and recrystallized to achieve an isolate of the highest purity.
The remaining mother liquor solution often contains a small amount of the target crystalline compounds and other valuable botanical constituents found within the starting solute. Mother liquor can be collected over time and further purified, or it can be purged of solvent and utilized for its other constituents.

COOLING CRYSTALLIZATION STANDARD OPERATING PROCEDURE
Purpose
The purpose of this procedure is to provide detailed instructions for cooling crystallization utilizing heptane as the crystallization solvent.
Scope
This procedure applies to all lab technicians tasked with cooling crystalization.
Definitions/Acronyms
Personal Protection Equipment (PPE) Items worn to protect employees from exposure to hazardous materials and prevention of injury.
Safety Data Sheet (SDS) Provides useful information on chemicals, describing the hazards the chemical presents, and giving information on handling, storage, and emergency measures in case of an accident.
Mother Liquor The liquid mixture remaining after crystal filtration.
Distilled Oil In this application distilled oil will mean winterized, decarboxylated, and distilled botanical extract containing 80% or more of the target crystalline compound by weight.
Safety
SDS Sheets: Heptane
PPE: The following should be worn by all lab personnel while performing cooling crystallization:
Protective eyewear
Lab coat
Nitrile Gloves
Respirator
Shoe Covers
Hairnet
5. Hazard Identification
Preparation and Use:
Distilled oil will be mixed with heptane at a 3:1 ratio Heptane-to-distillate ratio. The solution will be heated then chilled.
Potential Hazards and Risks
See Heptane SDS for detailed risks.
6. Preparation
1. Heat distillate to 120F/48.88C using a convection oven until the distillate is vicious enough to be poured and transferred to the crystallization reactor.
2. Ensure there is adequate chilled heptane in a C1D2 freezer available for washing the reactor near the end of the process (1-5 Liters)
3. Ensure the crystallization reactor and all auxiliary support equipment are clean, operational, and grounded.
6. Procedure
Crystallization
Crystal Processing
Carefully transfer the isolate to a clean processing room.
Weigh and record the total isolate weight.
Prepare clean drying pans using clean gloves and tools. Place the isolate onto a parchment paper or a chemical resistant PTFE sheet, and distribute the isolate powder evenly onto vacuum oven trays with under half an inch of thickness per tray.
Ensure the ovens are clean and the vacuum system and cold trap are set up properly on the system.
Place the vacuum oven trays into the vacuum oven carefully and close the vacuum oven door sealing the system.
Set the vacuum oven to 60C/140F and pull the system under full vacuum, allowing the isolate to sit in the vacuum ovens for at least 12 hours.
Take a sample from the material and send it off for third-party analysis to confirm its potency and status free of residual solvent.



